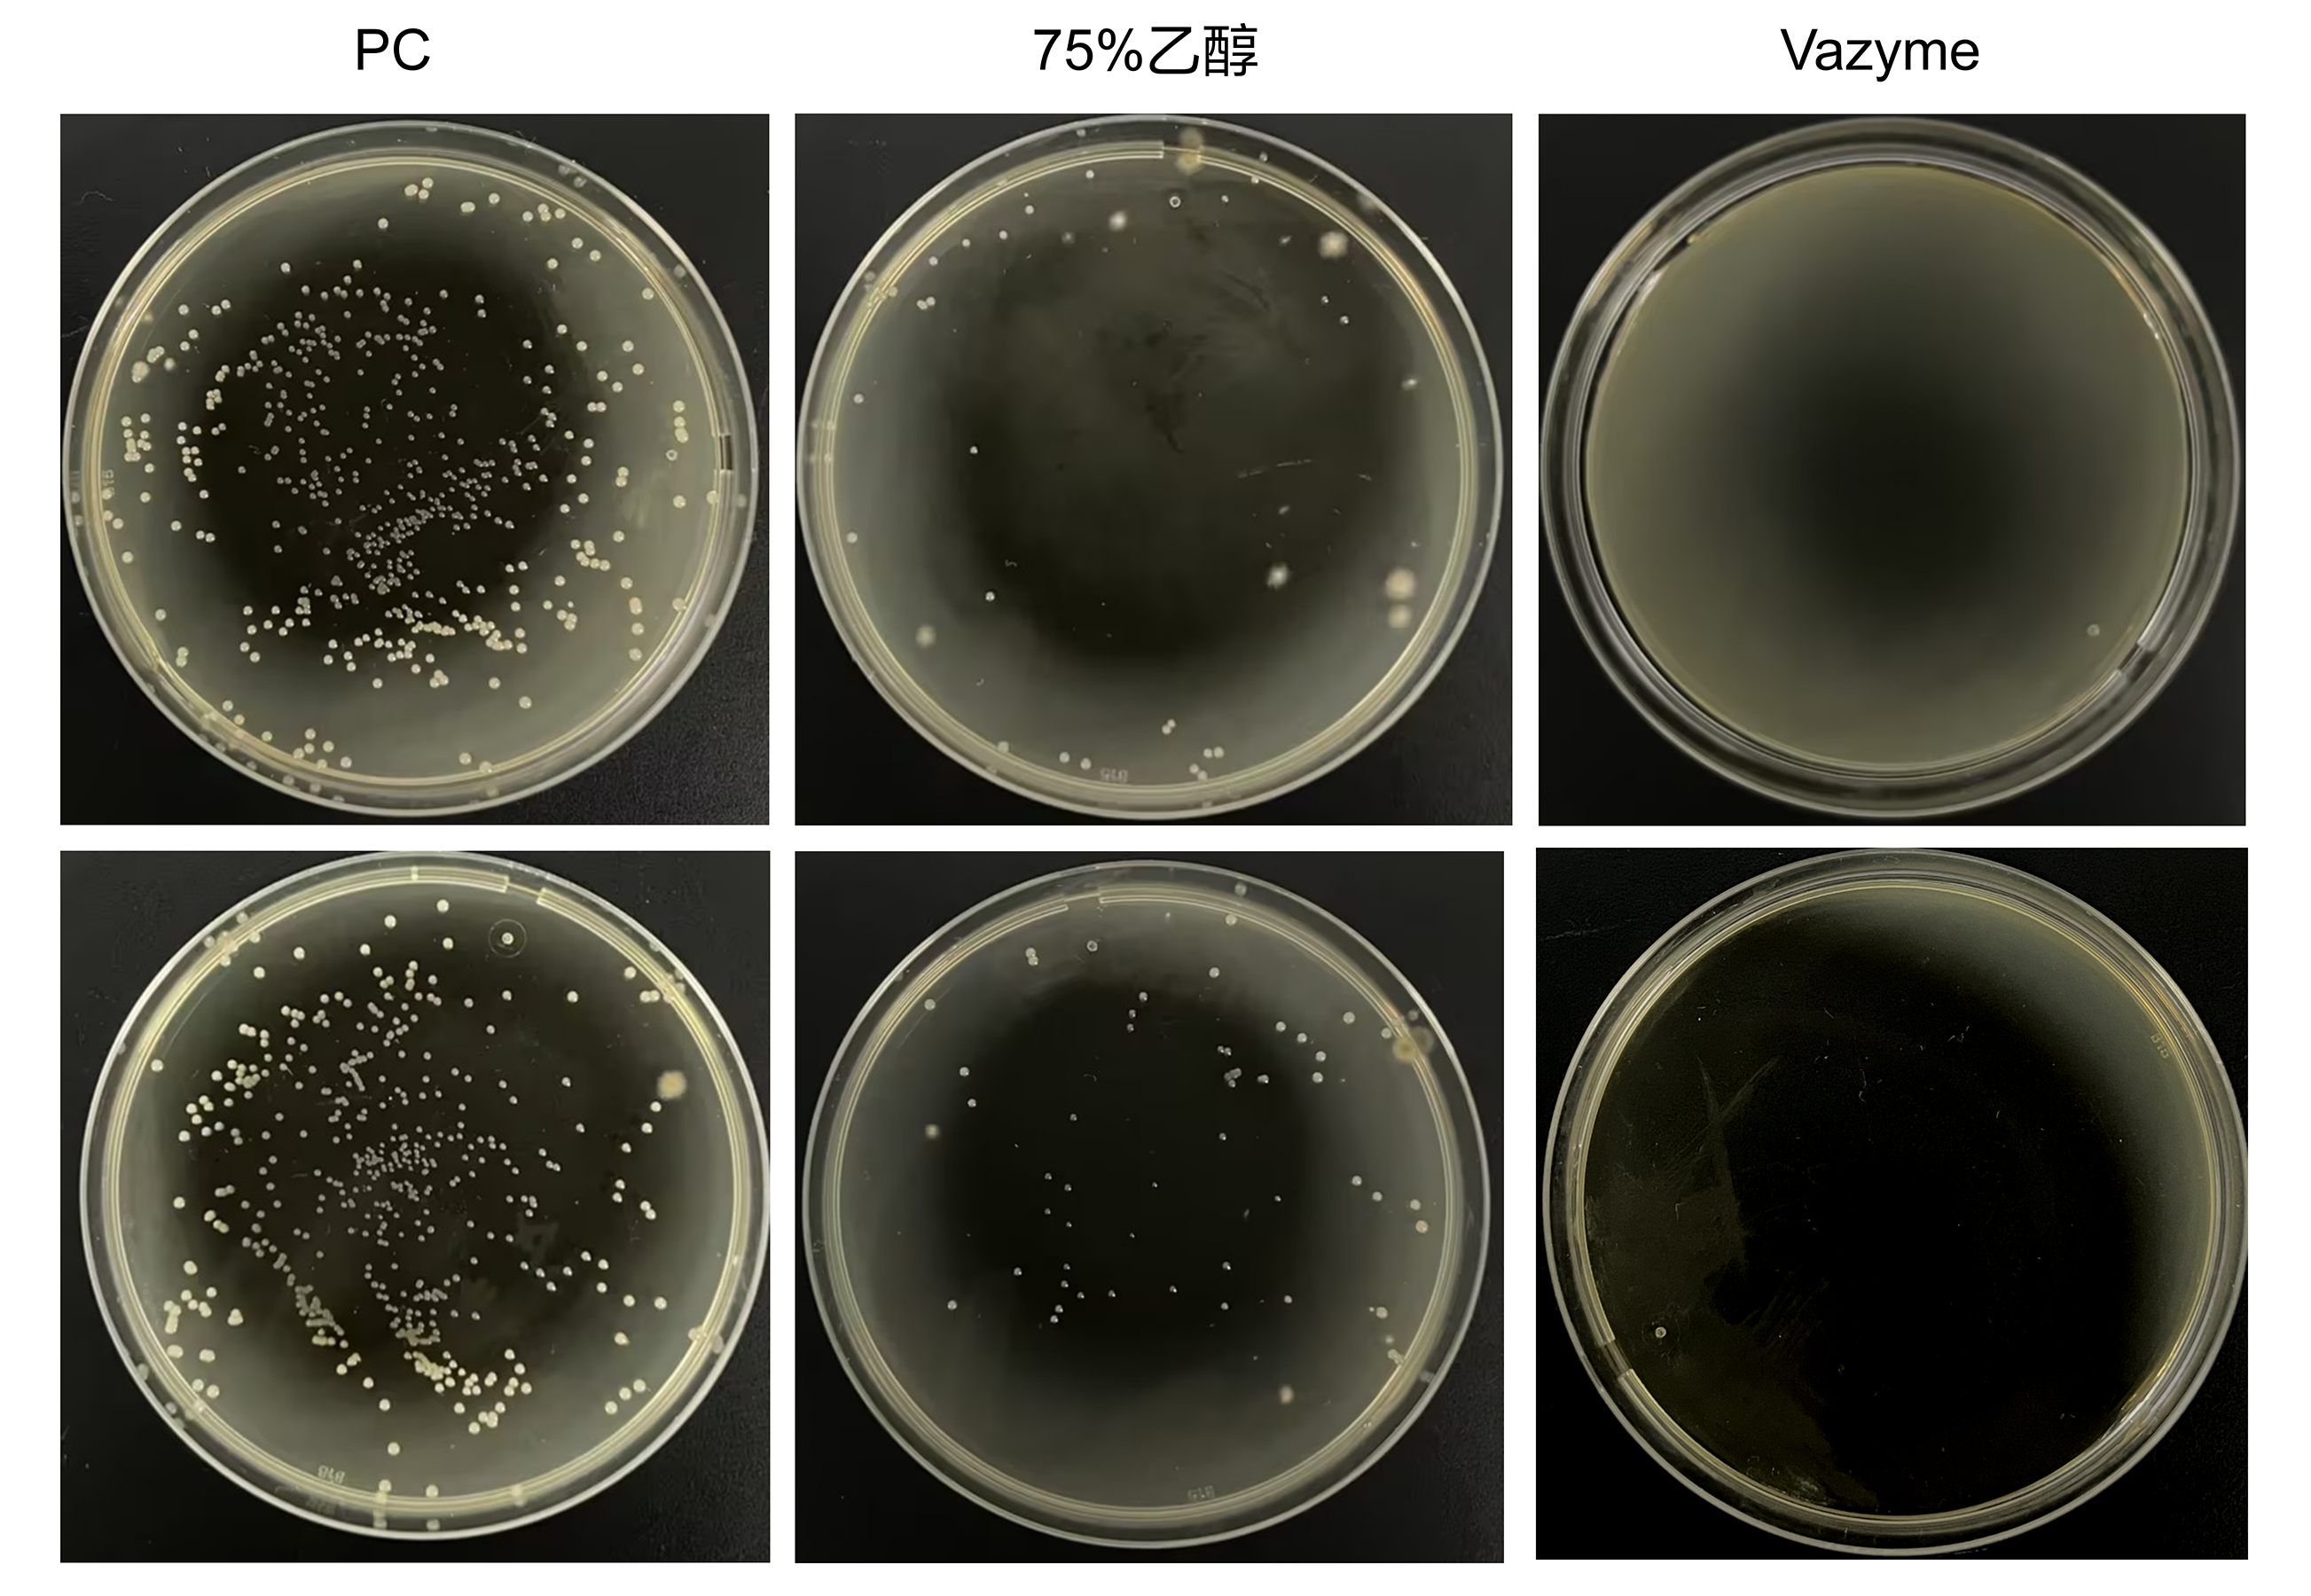
产品细节图片1

相关产品推荐更多 >
万千商家帮你免费找货
0 人在求购买到急需产品
- 详细信息
- 文献和实验
- 技术资料
- 规格:
250 ml
Surface Disinfectant Spray
环境除菌喷雾
一喷即净,“洁”界天成
产品应用
清除实验室台面、环境、墙壁、仪器中的细菌、真菌、支原体、部分病毒等。
产品描述
Surface Disinfectant Spray,即环境除菌喷雾,是一种起效作用快、针对多种微生物、安全无味、无设备腐蚀性的喷洒试剂,可用于减少和清除细胞房CO2培养箱、生物安全柜、操作台等设备表面的细菌、真菌、支原体以及部分病毒等污染物,保持细胞房环境的洁净,有效预防细胞污染。
产品优势
安全无味、起效作用快、无设备腐蚀性。
性能展示
1.抑菌性能
图1 抑菌测试结果
在TSA平板上涂布含菌环境样本,干燥后分别喷洒Vazyme #D302和75%乙醇,将平板开盖置于开放实验室环境中4天。结果显示D302抑菌效果更好。

图2 抑菌测试结果
在实验台面上选取同样大小区域,分别喷洒Vazyme #D302和75%乙醇,10分钟后用无菌拭子蘸取无菌PBS分别在各区域上下左右各5个来回擦拭取样,将拭子头投入LB液体培养基中培养,结果显示D302抑菌效果更好。
组分&说明
储存条件
15 ~ 25℃
风险提示:丁香通仅作为第三方平台,为商家信息发布提供平台空间。用户咨询产品时请注意保护个人信息及财产安全,合理判断,谨慎选购商品,商家和用户对交易行为负责。对于医疗器械类产品,请先查证核实企业经营资质和医疗器械产品注册证情况。
 文献和实验
文献和实验Automation of the Surface Sterilization System Procedure
input and increases the effectiveness and reproducibility of the surface sterilization treatment (1) (see Fig. 1). Numerous disinfectant types and techniques have been developed to surface sterilize plants (2). However, all procedures can be summarized
Immunostaining Thin Layer Chromatograms Of Glycolipids
side first, at a 45 degree angle. 3. Remove the plate and stand upright under a chemical fume hood to completely air dry. 4. Measure the surface area of the TLC plate. 5. Spray the TLC plate vigorously with PBS containing 1% BSA and then submerge
Polycrystalline thin films--质谱样品准备
several times to smear the deposit onto the surface and then remove the slide.Brush the crushed matrix with a tissue to remove any loose matrix particles.The layer of crushed matrix serves as the "activated" seeding site for the drying d roplet












